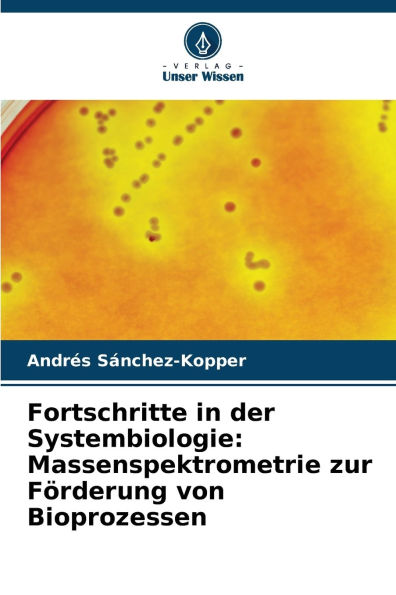
Fortschritte in der Systembiologie: Massenspektrometrie zur FÃ¯Â¿Â½rderung von Bioprozessen

Home
Online-Modell f�r problemorientiertes Lernen zur F�rderung des selbstgesteuerten Lernens
Barnes and Noble
Loading Inventory...
Online-Modell f�r problemorientiertes Lernen zur F�rderung des selbstgesteuerten Lernens in Franklin, TN
Current price: $68.00

Barnes and Noble
Online-Modell f�r problemorientiertes Lernen zur F�rderung des selbstgesteuerten Lernens in Franklin, TN
Current price: $68.00
Loading Inventory...
Size: OS
In dieser Forschungsarbeit wird ein Online-Modell für problembasiertes Lernen (PBL) entwickelt und evaluiert, um das selbstregulierte Lernen (SRL) von Studierenden zu fördern. Es wird ein Ansatz mit gemischten Methoden verwendet, der Expertenbewertungen und eine Versuchsimplementierung umfasst und eine signifikante positive Auswirkung auf die SRL-Werte zeigt. Das Modell legt den Schwerpunkt auf selbstgesteuertes Lernen, Zusammenarbeit und die Unterstützung durch den Lehrenden in einer digitalen Umgebung. Der Bericht ist in sechs Kapitel gegliedert, die eine Literaturübersicht, Methodik, Ergebnisse, Diskussion, Schlussfolgerungen und Empfehlungen umfassen. Zu den wichtigsten Themen gehören Online-Lernmodelle, PBL, SRL und die Entwicklung und Bewertung eines innovativen Online-Lernrahmens.
In dieser Forschungsarbeit wird ein Online-Modell für problembasiertes Lernen (PBL) entwickelt und evaluiert, um das selbstregulierte Lernen (SRL) von Studierenden zu fördern. Es wird ein Ansatz mit gemischten Methoden verwendet, der Expertenbewertungen und eine Versuchsimplementierung umfasst und eine signifikante positive Auswirkung auf die SRL-Werte zeigt. Das Modell legt den Schwerpunkt auf selbstgesteuertes Lernen, Zusammenarbeit und die Unterstützung durch den Lehrenden in einer digitalen Umgebung. Der Bericht ist in sechs Kapitel gegliedert, die eine Literaturübersicht, Methodik, Ergebnisse, Diskussion, Schlussfolgerungen und Empfehlungen umfassen. Zu den wichtigsten Themen gehören Online-Lernmodelle, PBL, SRL und die Entwicklung und Bewertung eines innovativen Online-Lernrahmens.